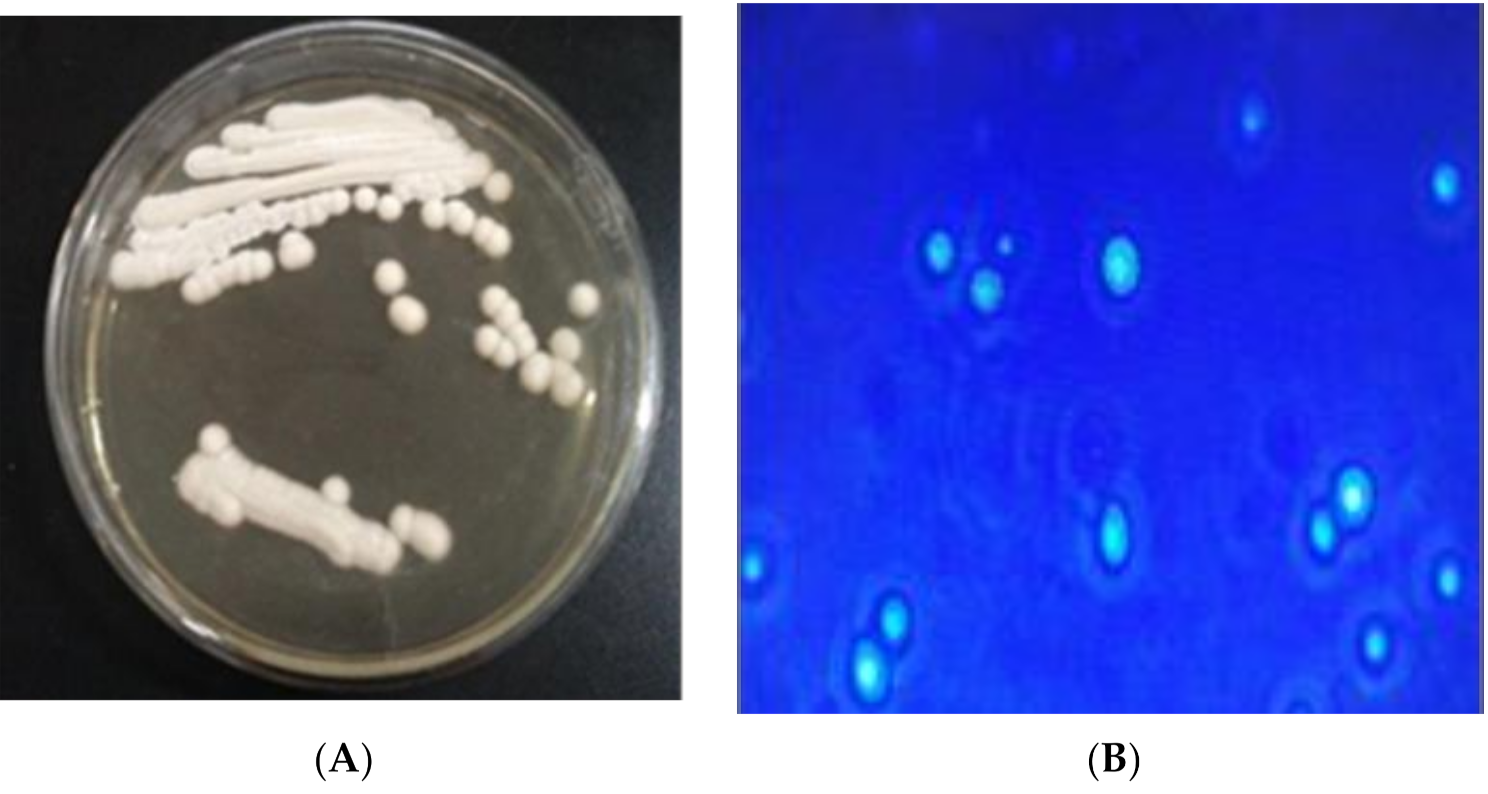

Isolation, Identification and Function of Pichia anomala AR2016 and Its Effects on the Growth and Health of Weaned Pigs
Abstract
Simple Summary
Abstract
1. Introduction
2. Materials and Methods
2.1. The Isolation, Identification, Heat Tolerance, Bile Salt Tolerance, and Artificial Gastric and Intestinal Juice Tolerance of P. anomala AR2016
2.1.1. Microorganisms, Culture Media, and Reagents
2.1.2. Isolation and 26S rDNA D1/D2 Identification of P. anomala
2.1.3. Anti Candida Albicans Test
2.1.4. Optimization of Culture Conditions for Strain AR2016
2.1.5. Resistance Testing of Strain P. anomala AR2016
2.2. Experimental Design and Dietary Composition for Pigs
2.2.1. Microorganisms and Reagents
2.2.2. Use and Care of Pigs
2.2.3. Growth Performance and Incidence of Diarrhea
2.2.4. Measurements and Sampling
2.2.5. Serum Biochemical Index Analysis
2.2.6. Hematoxylin-Eosin Staining
2.2.7. Western Blot Analysis
2.2.8. Real-Time Reverse Transcription-Polymerase Chain Reaction
2.2.9. Cecum Microflora Sequencing
2.2.10. Determination of Microbial Decarboxylase in the Jejunum and Ileum
2.3. Data Calculation and Statistical Analysis
3. Results
3.1. Optimal Culture of P. anomala AR2016
3.1.1. The Colony Characteristics of the Strain P. anomala AR2016
3.1.2. Physiological and Biochemical Characteristics of AR2016
3.1.3. Optimization of Culture Conditions for AR2016
3.1.4. The Resistance of AR2016
3.2. Effects of P. anomala AR2016 on Growth and Health of Weaned Pigs
3.2.1. Growth Performance and Diarrhea Incidence
3.2.2. Plasma Biochemical Index
3.2.3. Digestive Enzyme Activity of Weaned Pigs
3.2.4. Structure of Ileal Mucosa of Weaned Pigs
3.2.5. Occludin, ZO-1, and β-defensin-2 Concentrations in Intestinal Mucosa
3.2.6. The mRNA Level of ALP, APN, TLR-2, TNF-α, and IL-10 in the Intestinal Mucosa
3.2.7. Microbial Amino Acids Decarboxylase Activity
3.2.8. Microflora of Cecum of Weaned Pigs
4. Discussion
5. Conclusions
6. Patents
Supplementary Materials
Author Contributions
Funding
Institutional Review Board Statement
Data Availability Statement
Conflicts of Interest
References
- Everaert, N.; Cruchten, S.V.; Weström, B.; Bailey, M.; Van Ginneken, C.; Thymann, T.; Pieper, R. A review on early gut maturation and colonization in pigs, including biological and dietary factors affecting gut homeostasis. Anim. Feed Sci. Technol. 2017, 233, 89–103. [Google Scholar] [CrossRef]
- Liao, S.F.; Nyachoti, M. Using probiotics to improve swine gut health and nutrient utilization. Anim. Nutr. 2017, 3, 331–343. [Google Scholar] [CrossRef] [PubMed]
- Izgu, F.; Altlnbay, D.; Acun, T. Killer toxin of Pichia anomala NCYC 432 purification, characterization and its exo-β-1,3-glucanase activity. Enzyme Microb. Technol. 2006, 39, 669–676. [Google Scholar] [CrossRef]
- Antunes, J.; Aguiar, C. Search for killer phenotypes with potential for biological control. Ann. Microb. 2012, 62, 427–433. [Google Scholar] [CrossRef]
- De Melo, E.A.; Rosa, D.L.R.M.; Laranjeira, D.; Dos Santos, L.A.; Luciana, D.O.G.; Elineide, B.D.S. Efficacy of yeast in the biocontrol of bacterial fruit blotch in melon plants. Trop. Plant Pathol. 2015, 40, 56–64. [Google Scholar] [CrossRef]
- Olstorpe, M.; Passoth, V. Pichia anomala in grain biopreservation. Antonie Leeuwenhoek 2011, 99, 57–62. [Google Scholar] [CrossRef]
- Vohra, A.; Kaur, P.; Satyanarayana, T. Phytase production by the yeast, Pichia anomala. Biotech. Lett. 2012, 23, 551–554. [Google Scholar] [CrossRef]
- Tayel, A.A.; El-Tras, W.F.; Moussa, S.H.; El-Agamy, M.A. Antifungal action of Pichia anomala against aflatoxigenic Aspergillus flavus and its application as a feed supplement. J. Sci. Food. Agric. 2013, 93, 3259–3263. [Google Scholar] [CrossRef]
- Peng, Y.; Chi, Z.M.; Wang, X.H. Purification and molecular characterization of exo-β-1,3-glucanases from the marine yeast Williopsis saturnus WC91-2. Appl. Microbiol. Biotechnol. 2009, 85, 85–94. [Google Scholar] [CrossRef]
- Peng, Y.; Chi, Z.; Wang, X.; Li, J. β-1,3-glucanase inhibits activity of the killer toxin produced by the marine-derived yeast williopsis saturnus WC91-2. Mar. Biotechnol. 2010, 12, 479–485. [Google Scholar] [CrossRef]
- Peng, Y.; Liu, G.L.; Yu, X.J.; Wang, X.; Li, J.; Chi, Z. Cloning of exo-β-1,3-gluca-nase gene from a marine yeast Williopsis saturnus and its overexpression in yarrowia lipolytica. Mar. Biotechnol. 2011, 13, 193–204. [Google Scholar] [CrossRef]
- Ma, Y.J.; Lu, C.W.; Chen, Q.J.; Tang, Z.R. Effects orally Pichia anonmala AR2016 on growth performance and safety of Kunming mice. Chin. J. Anim. Nutr. 2019, 31, 1451–1462. [Google Scholar]
- Thanh, V.N.; Van Dyk, M.S.; Wingfield, M.J. Debaryomyces mycophilus sp. nov. a siderophore-dependent yeast isolated from woodlice. FEMS Yeast Res. 2002, 2, 415–427. [Google Scholar] [CrossRef]
- Salek, A. Transmission of killer activity into laboratory and industrial strains of Saccharomyces cerevisiae by electroinjection. FEMS Microbiol. Lett. 1990, 70, 67–72. [Google Scholar] [CrossRef][Green Version]
- Wang, Y.; Xu, M.; Wang, F.N.; Yu, Z.P.; Yao, J.H.; Zan, Z.S.; Yang, F.X. Effect of dietary starch on rumen and small intestine morphology and digesta pH in goats. Livest. Sci. 2009, 122, 48–52. [Google Scholar] [CrossRef]
- Edgar, R.C. UPARSE: Highly accurate OTU sequences from microbial amplicon reads. Nat. Methods 2013, 10, 996–998. [Google Scholar] [CrossRef]
- Chi, Z.M.; Liu, G.; Zhao, S.; Li, J.; Peng, Y. Marine yeasts as bio-control agents and producers of bio-products. Appl. Microb. Biotech. 2010, 86, 1227–1241. [Google Scholar] [CrossRef] [PubMed]
- Guo, H.L.; Cui, Y.; Zhu, E.L.; Wang, C.X. Effect of antagonistic yeast Pichia membranaefaciens, on black spot decay of postharvest broccoli. Eur. J. Plant. Pathol. 2015, 143, 373–383. [Google Scholar] [CrossRef]
- Tang, Z.R.; Deng, H.; Sun, W.Z.; Zhang, X.L.; Zhang, Z. Study on the mechanism of orally administered probiotics Escherichia coli Nissle 1917 regulating intestine barrier in weaned piglets. Anim. Feed. Sci. Technol. 2014, 45, 78–86. [Google Scholar] [CrossRef]
- Guo, X.Y.; Xie, C.Y.; Wu, Y. Effects of dietary supplement with xylo-oligosaccharide and active yeast during lactation of sows on reproduction performance and serum biochemical indices of suckling piglets. Chin. J. Anim. Nutr. 2015, 27, 838–844. [Google Scholar]
- Mera, J.R.; Dickson, B.; Feldman, M. Influence of gender on the ratio of serum aspartate aminotransferase (AST) to alanine aminotransferase (ALT) in patients with and without hyperbilirubinemia. Dig. Dis. Sci. 2008, 53, 799–802. [Google Scholar] [CrossRef]
- Campbell, J.M.; Crenshaw, J.D.; Polo, J. The biological stress of early weaned piglets. J. Anim. Sci. Biotech. 2013, 4, 124–127. [Google Scholar] [CrossRef] [PubMed]
- Melo, A.D.B.; Silvira, H.; Luciano, F.B.; Andrade, C.; Costa, L.B.; Rostagno, M.H. Intestinal alkaline phosphatase: Potential roles in promoting gut health in weanling piglets and its modulation by feed additives. Asian-Australas. J. Anim. Sci. 2016, 29, 16–22. [Google Scholar] [CrossRef][Green Version]
- Tang, Z.R.; Deng, H.; Zhang, X.L.; Zen, Y.; Xiao, D.F.; Sun, W.Z.; Zhang, Z. Effects of orally administering the antimicrobial peptide buforin II on small intestinal mucosal membrane integrity, the expression of tight junction proteins and protective factors in weaned piglets challenged by enterotoxigenic Escherichia coli. Anim. Feed Sci. Technol. 2013, 186, 177–185. [Google Scholar] [CrossRef]
- Gallardo, P.; Izquierdo, M.; Vidal, R.M.; Soto, F.; Ossa, J.C.; Farfan, M.J. Gut microbiota-metabolome changes in children with diarrhea by diarrheagenic E. coli. Front. Cell. Infect. Microb. 2020, 10. [Google Scholar] [CrossRef]
- Lai, X.; Xu, L.; Shi, B.S.; Liu, J.Y.; Deng, H.; Mao, J.X.; Tang, Z.R. Effects of crude protein levels on intestinal microbial enzyme avtivity of growth fattening pigs. Chin. J. Vet. Med. 2017, 37, 327–333. [Google Scholar] [CrossRef]
- Edward, A.B.P.; Jong-Pyo, C.; Marilen, P.B.; Hyeun, B.K.; Dae-Kyung, K. Assessment of fecal bacterial diversity among healthy piglets during the weaning transition. J. Gen. Appl. Microbiol. 2014, 60, 140–146. [Google Scholar] [CrossRef]
- Thomas, F.; Hehemann, J.H.; Rebuffet, E.; Czjzek, M.; Michel, G. Environmental and gut bacteroidetes: The food connection. Front. Microbiol. 2011, 2, 93. [Google Scholar] [CrossRef]
- Liu, H.Z.; Zhang, M.H.; Li, S.X. Effects of probiotic preparation on intestinal pH, mucosal morphology and volatile fatty acid content in early weaner piglets. Chin. J. Anim. Nutr. 2012, 24, 1329–1335. [Google Scholar]
- De Menezes, A.B.; Lewis, E.; O’Donovan, M.; O’Neill, B.F.; Clipson, N.; Doyle, E.M. Microbiome analysis of dairy COWS fed pasture or totaI mixed ration diets. FEMS Microbiol. Ecol. 2011, 78, 256–265. [Google Scholar] [CrossRef]
- Meehan, C.J.; Beiko, R.G. A phylogenomic view of ecological specialization in the lachnospiraceae, a family of digestive tract-associated bacteria. Genome Biol. Evol. 2014, 6, 703–713. [Google Scholar] [CrossRef]
- van Nood, E.; Vrieze, A.; Nieuwdorp, M.; Fuentes, S.; Zoetendal, E.G.; de Vos, W.M.; Visser, C.E.; Kuijper, E.J.; Bartelsman, J.F.; Tijssen, J.G.; et al. Duodenal infusion of donor feces for recurrent Clostridium difficile. N. Engl. J. Med. 2013, 368, 407–415. [Google Scholar] [CrossRef] [PubMed]
- Bandelj, P.; Blagus, R.; Briski, F.; Frlic, O.; Rataj, A.V.; Rupnik, M.; Ocepek, M.; Vengust, M. Identification of risk factors influencing Clostridium difficile prevalence in middle-size dairy farms. Vet. Res. 2016, 47, 41. [Google Scholar] [CrossRef] [PubMed]
- Waititu, S.M.; Heo, J.M.; Patterson, R.; Nyachoti, C.M. Dietary yeast-based nucleotides as an alternative to in-feed antibiotics in promoting growth performance and nutrient utilization in weaned pigs. Can. J. Anim. Sci. 2016, 1, 289–293. [Google Scholar] [CrossRef]
- Kiros, T.G.; Luise, D.; Derakhshani, H.; Petri, R.; Trevisi, P.; D’Inca, R.; Auclair, E.; van Kessel, A.G. Effect of live yeast Saccharomyces cerevisiae supplementation on the performance and cecum microbial profile of suckling piglets. PLoS ONE 2019, 14, e0219557. [Google Scholar] [CrossRef] [PubMed]

| Ingredients | Content | Nutritional Level 3 | Content |
|---|---|---|---|
| Corn crude protein 8% | 62.98 | Digestive energy /(MJ/kg) | 13.81 |
| Soybean meal CP 43% | 19.90 | Crude protein | 16.50 |
| Fish meal CP 65% | 2.40 | Ca | 0.73 |
| Whey | 5.65 | Crude Fibre | 2.60 |
| Wheat Bran | 5.08 | Absorbable P | 0.37 |
| Soybean oil | 0.85 | Lysine (Lys) | 1.27 |
| Limestone | 0.77 | Methionine (Met) | 0.37 |
| Salt | 0.30 | Threonine (Thr) | 0.75 |
| CaHPO4 | 0.70 | Tryptophan (Trp) | 0.22 |
| Sweetener | 0.06 | ||
| Antioxidant | 0.02 | ||
| Choline chloride | 0.08 | ||
| Vitamin premix 1 | 0.08 | ||
| Trace mineral premix 2 | 0.30 | ||
| Threonine (Thr) | 0.09 | ||
| Lysine Hydrochloride | 0.31 | ||
| Methionine (Met) | 0.09 | ||
| Tryptophan (Trp) | 0.34 | ||
| Total | 100.00 |
| Genes | Product Size and Accession No. | Primer Sequence (5′→3′) | Tm Value |
|---|---|---|---|
| Glyceraldehyde-3-phosphate dehydrogenase | 168 bp NM_001206359.1 | F:AAGGTCGGAGTGAACGGATT R:GACTGTGCCGTGGAACTTG | 59 °C |
| Alkaline phosphatase | 199 bp XM_021097682.1 | F:CCAAGCTCAGCAGACCCTAAA R:CAGGGCCACATAGGGAAACT | 60 °C |
| Aminopeptidase N | 114 bp NM_214277.1 | F:GGACGATTGGGTCTTGCTGA R:GGGATGACCGACAGGTTTGT | 60 °C |
| Toll-like receptors 2 | 112 bp NM_213761.1 | F:CTCTGTCTTGTGACCCTGCT R:CCCACATAGGCGATCCTGTT | 55 °C |
| Tumor necrosis factor-α | 113 bp NM_214022.1 | F:AACCTCAGATAAGCCCGTCG R:CTTTCAGCTTCACGCCGTTG | 60 °C |
| Interleukin-10 | 124 bp NM_214041.1 | F:CAGATGGGCGACTTGTTGCT R:CACTCTTGGCCTTCGGCATT | 60 °C |
| Carbon Source | Results | Carbon Source | Results |
|---|---|---|---|
| Galactose | + | Acetamide | + |
| Sucrose | + | Mannitol | + |
| Fiber disaccharide | + | Rhamnose | + |
| Raffinose | − | Melibiose | − |
| Sorbitol | + | Xylose | + |
| Melezitose | + | Ribose | + |
| Inositol | + | Glycerin | + |
| Trehalose | + | Arabinose | + |
| Items | Groups 1 | SEM 2 | p-Value | ||
|---|---|---|---|---|---|
| CK | C. utilis | P. anomala | |||
| Initial weight/kg | 7.34 | 7.46 | 7.65 | 0.23 | 0.63 |
| Final weight/kg | 11.9 c | 13.8 b | 15.0 a | 0.29 | <0.001 |
| Average daily gain gain/(g/d) | 163 b | 226 a | 262 a | 13.2 | <0.001 |
| Average daily feed intake/(g/d) | 370 b | 450 a | 470 a | 17.5 | 0.01 |
| Feed conversion rate | 0.44 b | 0.50 a | 0.56 a | 0.10 | 0.04 |
| Items | Groups 1 | SEM 2 | p-Value | ||
|---|---|---|---|---|---|
| CK | C. utilis | P. anomala | |||
| Glucose (mmol/L) | 2.52 c | 5.19 a | 3.50 b | 0.20 | <0.01 |
| Total protein (g prot/L) | 47.6 c | 57.6 a | 53.7 b | 0.68 | <0.01 |
| Total superoxide dismutase (U/mg L) | 29.9 c | 54.4 b | 57.8 a | 1.06 | <0.01 |
| Total antioxidative capacity (U/mL) | 1.17 c | 2.71 b | 22.30 a | 0.40 | <0.01 |
| Glutathione peroxidase (U/mg L) | 482 c | 518 b | 564 a | 1.00 | <0.01 |
| Malondialdehyde (nmoL/L) | 10.36 a | 2.54 b | 2.28 b | 0.155 | <0.01 |
| D-lactic acid (ng/μL) | 72.40 a | 39.46 b | 38.85 b | 1.072 | <0.01 |
| Endotoxin (EU/mL) | 0.182 a | 0.142 b | 0.112 c | 0.005 | <0.01 |
| Items | Groups 1 | SEM 2 | p-Value | ||
|---|---|---|---|---|---|
| CK | C. utilis | P. anomala | |||
| Jejunum | |||||
| Trypsin (U/mg prot) | 26.90 c | 28.40 b | 31.30 a | 0.304 | <0.01 |
| Amylase (U/mg prot) | 0.05 c | 0.07 b | 0.08 a | 0.003 | <0.01 |
| Lipase (U/mg prot) | 144 c | 346 a | 323 b | 4.327 | <0.01 |
| Ileum | |||||
| Trypsin (U/mg prot) | 29.53 b | 37.13 a | 39.25 a | 0.757 | <0.01 |
| Amylase (U/mg prot) | 0.09 | 0.09 | 0.09 | 0.003 | 0.93 |
| Lipase (U/mg prot) | 190 c | 340 a | 307 b | 6.986 | <0.01 |
| Villus height /(μm) | 253 b | 253 b | 354 a | 8.10 | 0.01 |
| Crypt depth /(μm) | 182 a | 147 b | 176 a | 4.46 | 0.02 |
| Villus height/crypt depth | 1.39 c | 1.73 b | 2.02 a | 0.04 | <0.01 |
| Items | Groups 1 | SEM 2 | p-Value | ||
|---|---|---|---|---|---|
| CK | C. utilis | P. anomala | |||
| Jejunum | |||||
| Alkaline phosphatase | 0.62 b | 0.78 a | 0.83 a | 0.04 | 0.01 |
| Aminopeptidase N | 0.24 | 0.23 | 0.19 | 0.02 | 0.17 |
| Toll-like receptors 2 | 0.31 b | 0.28 b | 0.48 a | 0.02 | <0.01 |
| Tumor necrosis factor-α | 0.21 c | 0.55 a | 0.37 b | 0.03 | <0.01 |
| Interleukin-10 | 0.96 | 1.28 | 1.21 | 0.07 | 0.05 |
| Ileum | |||||
| Alkaline phosphatase | 0.42 b | 0.51 a | 0.55 a | 0.02 | 0.01 |
| Aminopeptidase N | 0.26 a | 0.19 b | 0.14 b | 0.02 | 0.01 |
| Toll-like receptors 2 | 0.21 | 0.18 | 0.29 | 0.03 | 0.09 |
| Tumor necrosis factor-α | 0.19 c | 0.46 a | 0.36 b | 0.02 | <0.01 |
| Interleukin-10 | 0.82 | 1.15 | 1.09 | 0.05 | 0.05 |
| Items | Groups 1 | SEM 2 | p-Value | ||
|---|---|---|---|---|---|
| CK | C. utilis | P. anomala | |||
| Jejunum (U/mg) | |||||
| Arginine decarboxylase | 1.42 | 1.38 | 1.37 | 0.050 | 0.76 |
| Histidine decarboxylase | 1.61 a | 1.45 b | 1.40 b | 0.037 | <0.01 |
| Lysine decarboxylase | 1.44 | 1.41 | 1.35 | 0.029 | 0.17 |
| Methionine decarboxylase | 1.37 | 1.33 | 1.33 | 0.032 | 0.79 |
| tryptophan decarboxylase | 0.57 | 0.48 | 0.49 | 0.027 | 0.08 |
| Ileum (U/mg) | |||||
| Arginine decarboxylase | 1.64 | 1.61 | 1.65 | 0.014 | 0.15 |
| Histidine decarboxylase | 1.60 a | 1.44 b | 1.31 b | 0.019 | <0.01 |
| Lysine decarboxylase | 1.53 a | 1.35 b | 1.03 c | 0.008 | <0.01 |
| Methionine decarboxylase | 1.22 | 1.23 | 1.23 | 0.059 | 0.99 |
| tryptophan decarboxylase | 0.40 a | 0.33 b | 0.26 c | 0.014 | <0.01 |
| Items | Groups 1 | SEM 2 | p-Value | ||
|---|---|---|---|---|---|
| CK | C. utilis | P. anomala | |||
| Bacteroidetes | 59.90 b | 62.10 b | 66.50 a | 1.04 | 0.01 |
| Prevotellaceae | 48.96 | 50.63 | 52.94 | 0.97 | 0.07 |
| Firmicutes | 26.50 | 24.20 | 27.70 | 0.92 | 0.09 |
| Proteobacteria | 11.00 a | 10.70 a | 3.40 b | 0.30 | <0.01 |
| Lachnospiraceae | 10.92c | 12.22 b | 14.22 a | 0.27 | <0.01 |
| Bacteroidaceae | 7.58 | 6.40 | 6.72 | 0.40 | 0.18 |
| Actinobacteria | 5.40 a | 1.20 b | 1.10 b | 0.15 | <0.01 |
| Ruminococcaceae | 4.97 | 5.34 | 5.53 | 0.40 | 0.62 |
| Clostridiaceae | 4.75 a | 1.08 b | 1.40 b | 0.18 | <0.01 |
| Veillonellaceae | 3.09 | 3.50 | 3.66 | 0.22 | 0.25 |
| Lactobacillaceae | 2.89 a | 0.38 c | 1.29 b | 0.22 | <0.01 |
| Succinivibrionaceae | 1.72 b | 1.96 ab | 2.41 a | 0.14 | 0.04 |
| Acidaminococcaceae | 0.36 | 0.35 | 0.33 | 0.10 | 0.98 |
| Desulfovibrionaceae | 0.31 a | 0.05 b | 0.03 b | 0.02 | <0.01 |
| Enterobacteriaceae | 0.20 | 0.11 | 0.33 | 0.08 | 0.28 |
| Campylobacteraceae | 0.07 a | 0.08 a | 0.03 b | 0.01 | 0.02 |
Publisher’s Note: MDPI stays neutral with regard to jurisdictional claims in published maps and institutional affiliations. |
© 2021 by the authors. Licensee MDPI, Basel, Switzerland. This article is an open access article distributed under the terms and conditions of the Creative Commons Attribution (CC BY) license (https://creativecommons.org/licenses/by/4.0/).
Share and Cite
Ma, Y.; Sun, Z.; Zeng, Y.; Hu, P.; Sun, W.; Liu, Y.; Hu, H.; Rao, Z.; Tang, Z. Isolation, Identification and Function of Pichia anomala AR2016 and Its Effects on the Growth and Health of Weaned Pigs. Animals 2021, 11, 1179. https://doi.org/10.3390/ani11041179
Ma Y, Sun Z, Zeng Y, Hu P, Sun W, Liu Y, Hu H, Rao Z, Tang Z. Isolation, Identification and Function of Pichia anomala AR2016 and Its Effects on the Growth and Health of Weaned Pigs. Animals. 2021; 11(4):1179. https://doi.org/10.3390/ani11041179
Chicago/Turabian StyleMa, Yajun, Zhihong Sun, Yan Zeng, Ping Hu, Weizhong Sun, Yubo Liu, Hong Hu, Zebin Rao, and Zhiru Tang. 2021. "Isolation, Identification and Function of Pichia anomala AR2016 and Its Effects on the Growth and Health of Weaned Pigs" Animals 11, no. 4: 1179. https://doi.org/10.3390/ani11041179
APA StyleMa, Y., Sun, Z., Zeng, Y., Hu, P., Sun, W., Liu, Y., Hu, H., Rao, Z., & Tang, Z. (2021). Isolation, Identification and Function of Pichia anomala AR2016 and Its Effects on the Growth and Health of Weaned Pigs. Animals, 11(4), 1179. https://doi.org/10.3390/ani11041179






